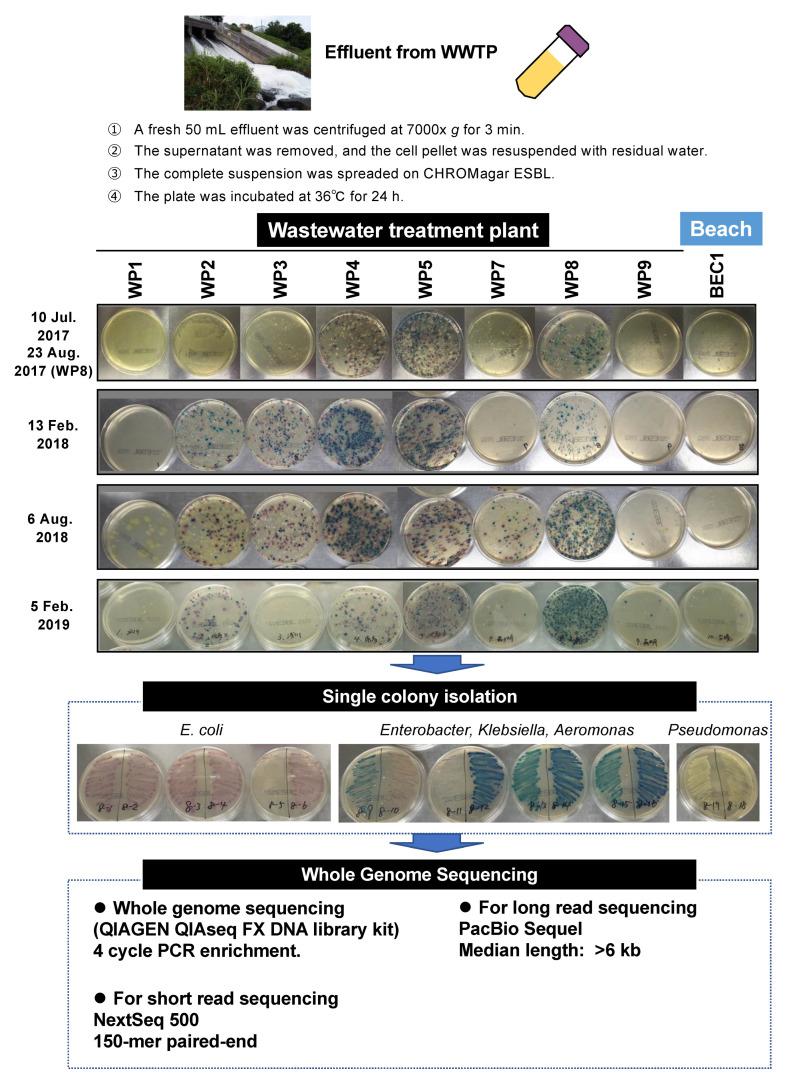

东京污水处理厂排放废水中耐药菌的全基因组和质粒组综合分析
Comprehensive Genome and Plasmidome Analysis of Antimicrobial Resistant Bacteria in Wastewater Treatment Plant Effluent of Tokyo.
作者信息
Sekizuka Tsuyoshi, Tanaka Rina, Hashino Masanori, Yatsu Koji, Kuroda Makoto
机构信息
Pathogen Genomics Center, National Institute of Infectious Diseases, Shinjyuku-ku, Tokyo 162-8640, Japan.
出版信息
Antibiotics (Basel). 2022 Sep 21;11(10):1283. doi: 10.3390/antibiotics11101283.
To characterize environmental antimicrobial resistance (AMR) in urban areas, extended-spectrum β-lactamase- (ESBL)/carbapenemase-producing bacteria (EPB/CPB, respectively) from urban wastewater treatment plant effluents in Tokyo were isolated on CHROMagar ESBL plate. Complete genome sequence analysis, including plasmids, indicated that 126 CTX-M-positive isolates (31%) were identified among the 404 obtained isolates. The CTX-M-9 group was predominant ( = 65, 52%), followed by the CTX-M-1 group ( = 44, 35%). Comparative genome analysis revealed that CTX-M-27-positive O16:H5-ST131- exhibited a stable genome structure and clonal-global dissemination. Plasmidome network analysis revealed that 304 complete plasmid sequences among 85 isolates were grouped into 14 incompatibility (Inc) network communities (Co1 to Co14). Co10 consisted of primarily IncFIA/IncFIB plasmids harboring in , whereas Co12 consisted primarily of IncFIA(HI1)/Inc FIB(K) plasmids harboring , , and in spp. Co11 was markedly located around Co10 and Co12. Co11 exhibited , , and , and was mainly detected in and spp. from human and animal sources, suggesting a mutual role of Co11 in horizontal gene transfer between and spp. This comprehensive resistome analysis uncovers the mode of relational transfer among bacterial species, highlighting the potential source of AMR burden on public health in urban communities.
为了表征城市地区的环境抗菌药物耐药性(AMR),在CHROMagar ESBL平板上分离了东京城市污水处理厂流出物中产生超广谱β-内酰胺酶(ESBL)/碳青霉烯酶的细菌(分别为EPB/CPB)。包括质粒在内的全基因组序列分析表明,在获得的404株分离株中,鉴定出126株CTX-M阳性分离株(31%)。CTX-M-9组占主导地位(=65,52%),其次是CTX-M-1组(=44,35%)。比较基因组分析显示,CTX-M-27阳性的O16:H5-ST131-表现出稳定的基因组结构和克隆性全球传播。质粒组网络分析表明,85株分离株中的304个完整质粒序列被分为14个不相容(Inc)网络群落(Co1至Co14)。Co10主要由携带的IncFIA/IncFIB质粒组成,而Co12主要由携带、和的IncFIA(HI1)/Inc FIB(K)质粒组成。Co11明显位于Co10和Co12周围。Co11表现出、和,主要在来自人和动物源的和中检测到,表明Co11在和之间的水平基因转移中起相互作用。这种全面的耐药组分析揭示了细菌物种之间的关系转移模式,突出了城市社区公共卫生中AMR负担的潜在来源。